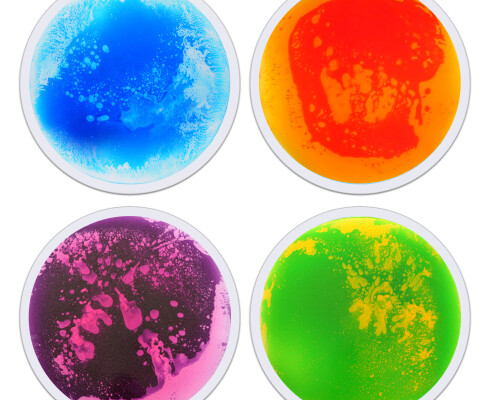
Round Liquid Floor Tiles 50x50cm 4 Colours

Floor and Wall Products
This is our current list of available items and more will be added on a regular basis.

Liquid Floor Tile Pink / Yellow

Liquid Floor Tile Red

Small Liquid Floor Tiles 30x30cm (pack Of 4 Colours)
Round Liquid Floor Tiles 50x50cm 4 Colours

Hexagon Liquid Floor Tile (set Of 4)

Quadrant Liquid Tile (set Of 4)

Equilateral Triangle Liquid Tiles (set Of 6)

Hopscotch Liquid Floor Tiles Pack Of 10 (40x40cm)

Sensory Liquid Glitter Filled Tile : Gold

Sensory Liquid Glitter Filled Tile : Silver

S/4 Aquatic Liquid Floor Tiles

Led Sensory Carpet

S/6 Textured Floor Tiles

Forest Padded Wall Art

Pencil Padded Wall Art
